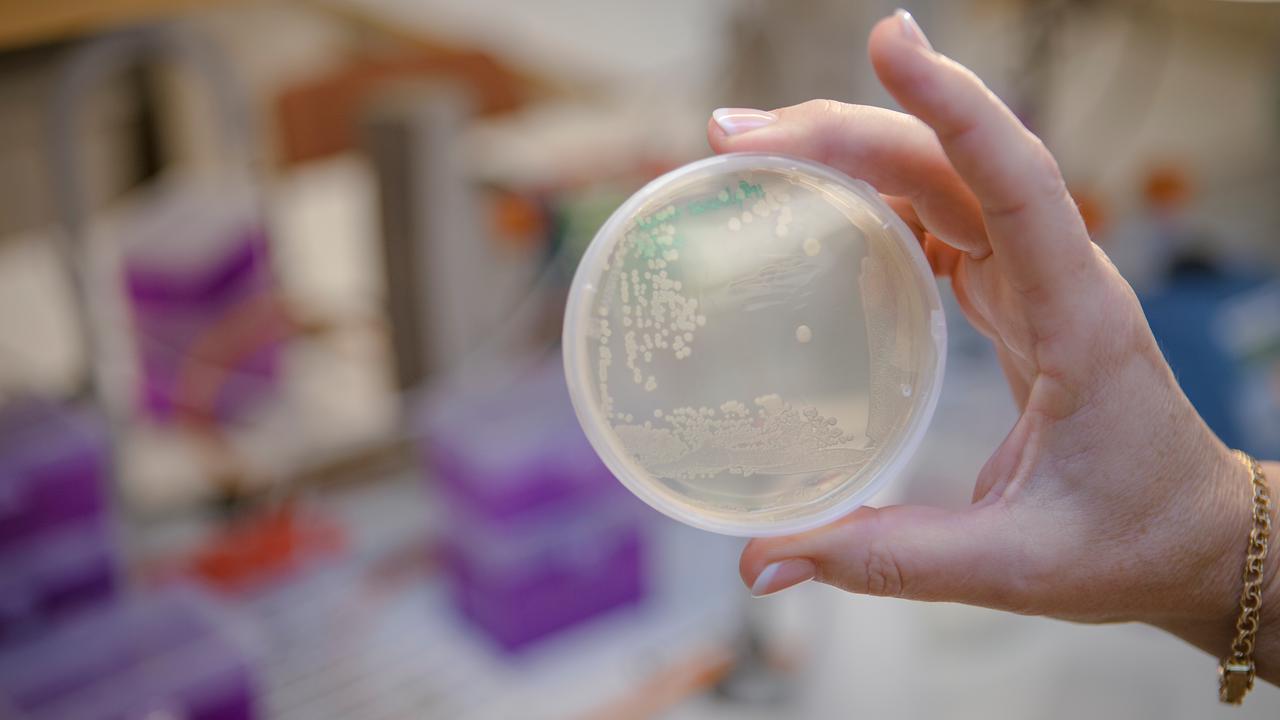

MIMS Spotlight Serie: Louise möter Monique Johnson
Louise Lindbäck pratade med Monique Johnson, en postdoktorand i Ellen Bushells laboratorium, som studerar interaktioner mellan malariaparasiter och värddjur.
Publicerad: 2025-09-24 Uppdaterad: 2025-12-03, 16:18 Text: Nora Lehotai

Monique Johnson på labb 2025
BildMariko DaleTräffa Monique Johnson
Som postdoktor vid MIMS utforskar hon den komplexa biologin hos malariaparasiter och utvecklar innovativa genetiska verktyg för att identifiera nya läkemedelsmål. Med en bakgrund som sträcker sig från Cambridge till Umeå förenar hennes arbete molekylära detaljer med storskaliga screeningar. Utanför labbet njuter hon av den svenska naturen men drömmer fortfarande om dykäventyr i varma hav. Nu träffar vi Monique!
Kan du berätta om din roll på MIMS och vad du arbetar med just nu?
"Jag är postdoktoral forskare i Ellen Bushells forskargrupp vid institutionen för molekylärbiologi, Umeå universitet. Jag arbetar med exporterade proteiner i gnagarmodellen för malaria, parasiten Plasmodium berghei, som används som en in vivo-modell för den mänskligt infekterande parasiten Plasmodium falciparum. Bushell-labbet utvecklar genetiska verktyg för att undersöka P. bergheis genfunktioner i stor skala, och vi är särskilt intresserade av de parasitgener som styr viktiga värd–parasit-interaktioner och bidrar till infektion och sjukdom. Gruppen har nyligen etablerat ett CRISPR-Cas9-system som möjliggör storskaliga knockout-screeningar, kallat PbHiT.
Jag fortsätter arbetet med PbHiT-systemet och anpassar det för att studera essentiella gener med hjälp av villkorliga knockdown-metoder. Tillsammans med andra i gruppen utvecklar jag två olika system som är skräddarsydda för antingen exporterade eller icke-exporterade proteiner, och som båda underlättar villkorlig fel-lokalisering av målproteinet. Detta gör det möjligt för oss att studera essentiella parasitgener för vilka livsdugliga knockout-mutanter inte kan erhållas. Vi utforskar också funktionerna i virulens och sekvestrering hos en uppsättning gener som, när de slås ut, ger upphov till långsam tillväxt in vivo – något som är unikt möjligt med den in vivo-modell som P. berghei erbjuder."
Vilken påverkan hoppas du att din forskning kommer att ha på ditt område och bortom det?
"Jag hoppas att vi med detta projekt kan tillhandahålla verktyg för att identifiera ett större antal läkemedelsmål mot malaria, samtidigt som vi själva utforskar några av dessa mål från screenarna, för att öka möjligheterna att identifiera läkemedel som kan minska sjukdomsbördan."
Vad gjorde du innan du började på MIMS, och vad lockade dig till att söka en tjänst här?
"Innan jag började på MIMS forskade jag för min doktorsexamen vid University of Cambridge med professor Catherine Merrick. Under min doktorandtid arbetade jag med cellcykelkontroller i den mänskligt infekterande malariaparasiten P. falciparum och en annan besläktad parasit, Toxoplasma gondii. Jag använde cellbaserade analyser, proteinuttryck, immunofluorescens och replikationsspårning för att undersöka den möjliga förekomsten av cellcykelkontroller och svar på DNA-skador. Jag fann dessa patogena parasiter, och de kunskapsluckor som finns kring deras fundamentalt avvikande eukaryota biologi, särskilt fascinerande.
Jag såg i ett mejl som vidarebefordrades av min handledare att Ellen sökte en postdoktor, och jag inspirerades av Bushell-labbets nya angreppssätt för att undersöka flera kandidater samtidigt i storskaliga screenar, något som ännu inte var möjligt i P. falciparum. Jag tyckte att projektet som beskrevs verkade vara något där jag kunde bidra med min bakgrund inom molekylärbiologi och min förståelse för malariaparasiter. Jag ville också lära mig mer om storskaliga genetiska screenar och hur man använder en in vivo-modell för att förstå malaria-infektioner genom värd–parasit-interaktioner."
Vad motiverade dig att bli postdoktoral forskare?
"Jag har verkligen uppskattat och känt mig motiverad i min forskning under både master- och doktorandprojekt. Plasmodium-parasiter är särskilt intressanta med de utmaningar det innebär att kunna förstå dem, deras fascinerande biologi och de problem som finns med nuvarande behandlingar. Jag ville fördjupa mig i infektionsbiologi hos denna organism på ett mer storskaligt sätt och undersöka värd–parasit-interaktioner (vilket är ett särskilt spännande område inom Plasmodium-biologi). Denna postdoktorstjänst kändes som ett naturligt steg för att utforska dessa organismer vidare på ett meningsfullt sätt, tillsammans med äventyret att flytta till Sverige för första gången."
Vad uppskattar du mest med att arbeta vid Umeå universitet?
"Den vänskapliga atmosfären, den stödjande kulturen inom postdoktorsgemenskapen och den spännande forskningen som sker både inom institutionen och vid resten av Umeå universitet, som vi ofta får höra om på olika seminarier."
Om du inte hade din nuvarande profession, vad tror du att du skulle göra då?
"Jag skulle kanske vara undervattensfotograf eller dykinstruktör i ett tropiskt område; jag älskar att dyka och utforska haven."
Två saker på min bucket list: Hoppa fallskärm. Resa runt i Vietnam och uppleva landets kultur och natur.
Föredraget sätt att koppla av: Ta promenader, utforska naturen och vistas nära älvar, sjöar eller hav.
Favoritsport eller aktivitet: "Jag har verkligen uppskattat att lära mig några nya vintersporter här i Umeå, som längdskidåkning."
Infektionsbiologi
Infektionsbiologi är ett forskningsområde där Umeå universitet ligger i framkanten.

Institutionen för molekylärbiologi
Institutionen är knuten till både teknisk-naturvetenskapliga fakulteten och medicinska fakulteten.

Ellen Bushell lab
Gruppen studerar interaktioner mellan parasiter och värdar som styr malariainfektioner och sjukdomar.







